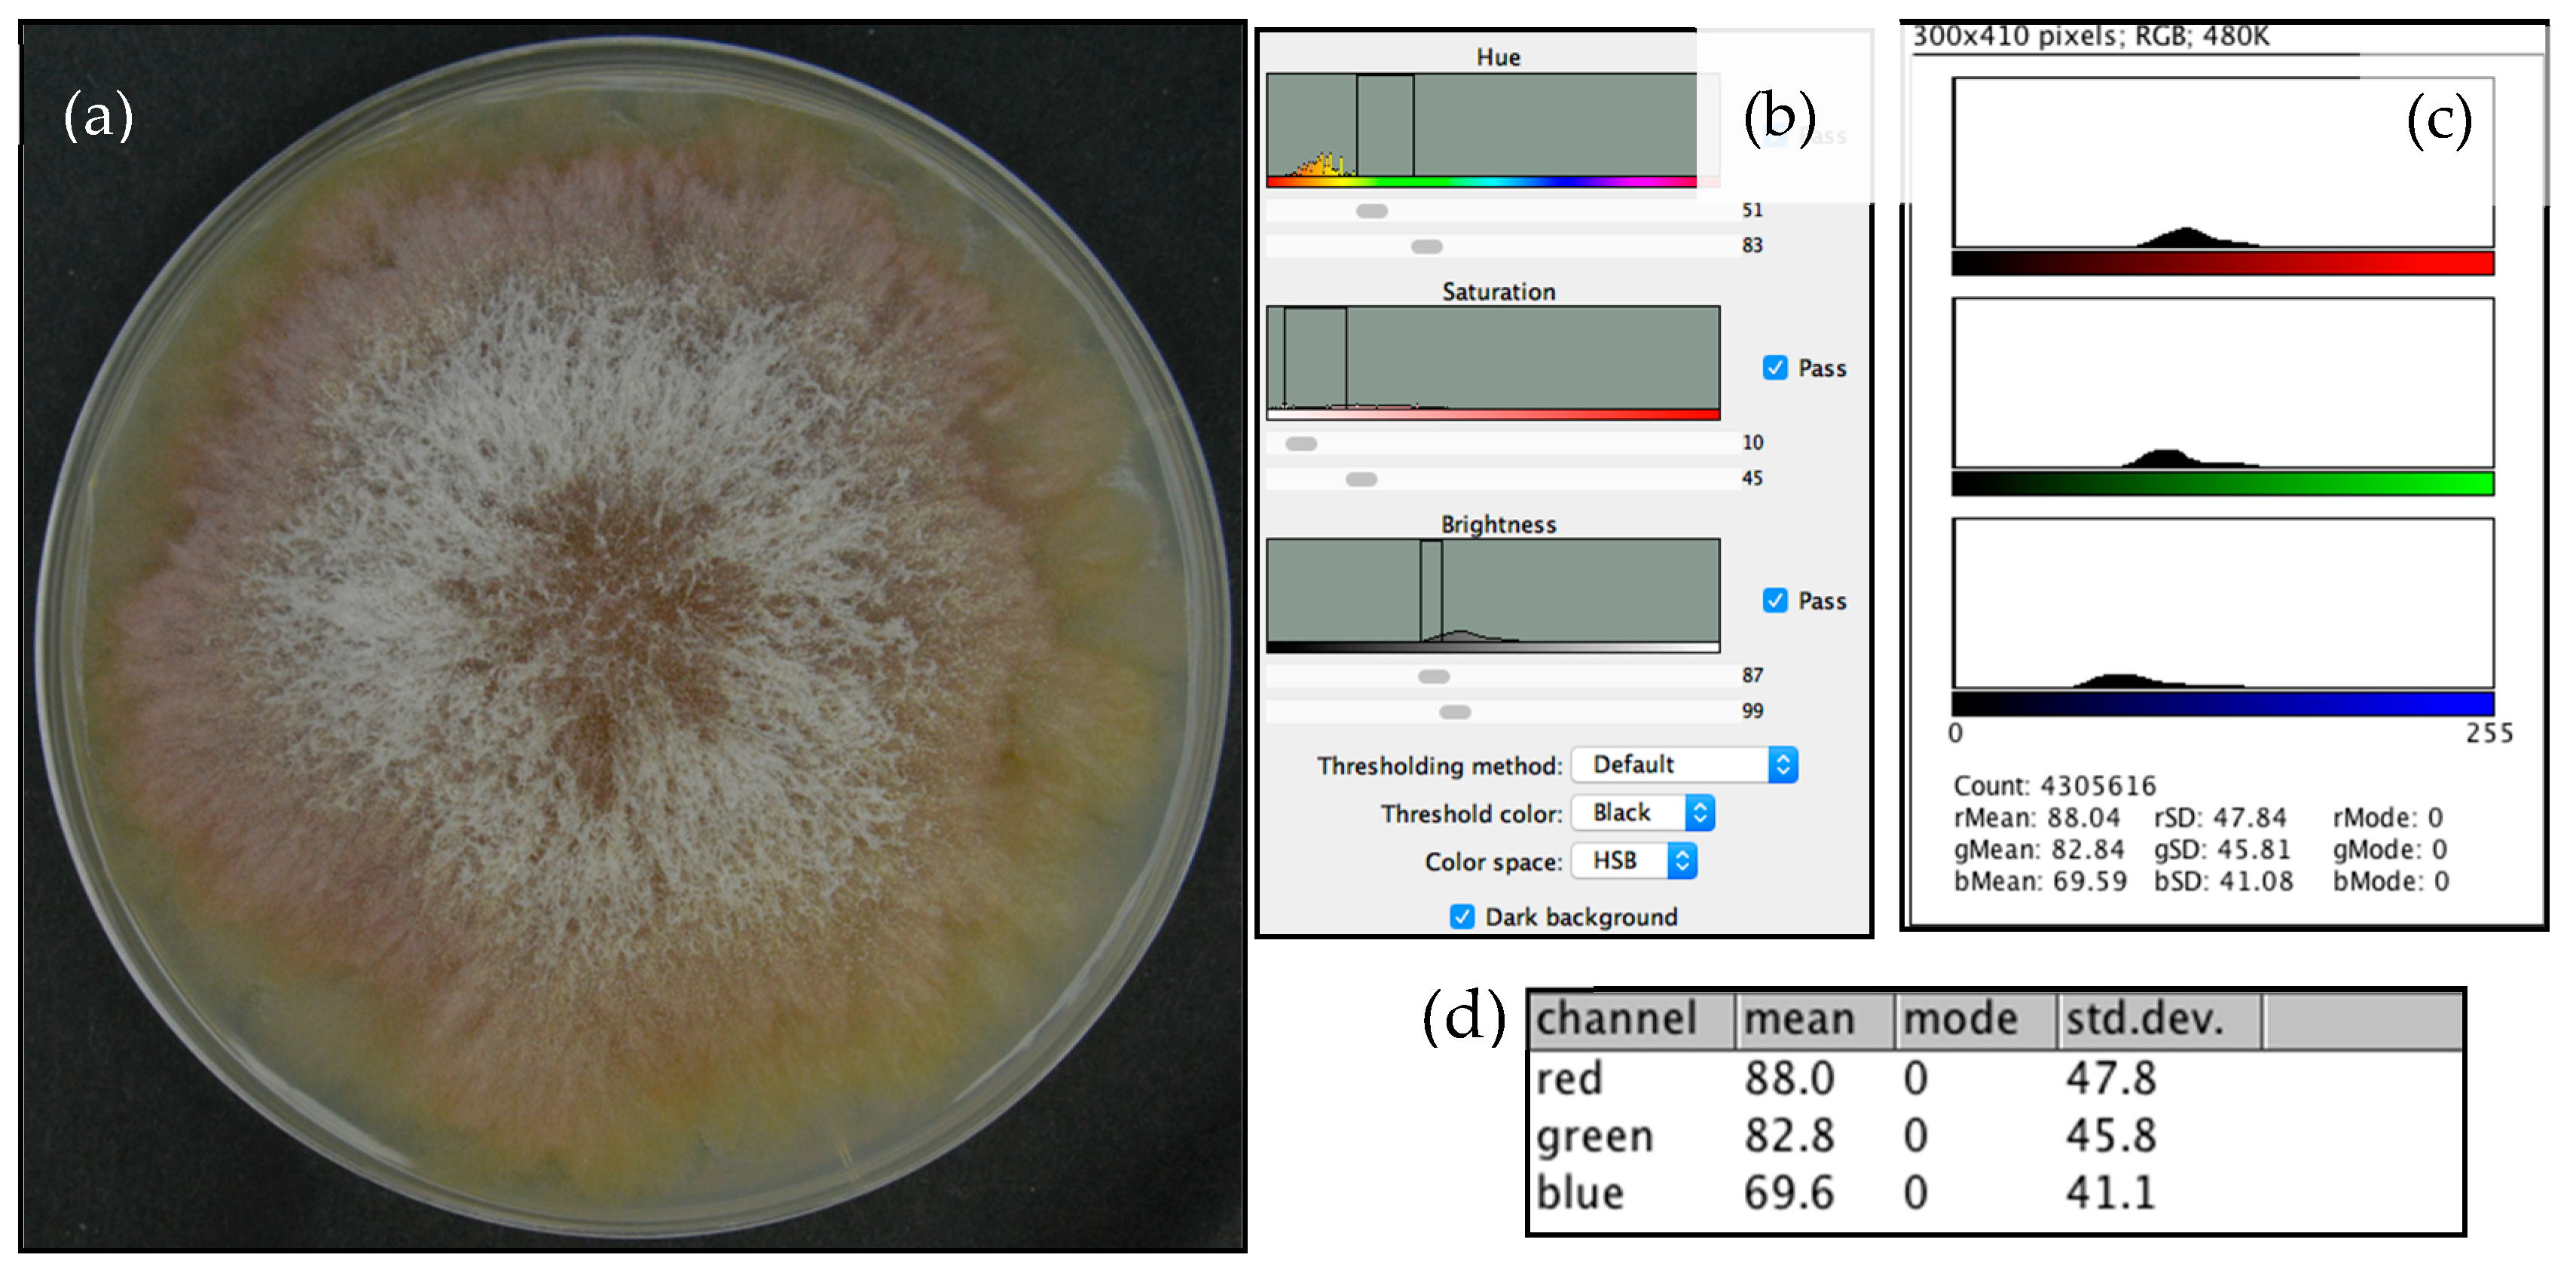
Foods 08 00007 g002

Fusarium graminearum Colors and Deoxynivalenol Synthesis at Different Water Activity
Abstract
1. Introduction
2. Materials and Methods
2.1. Mold Isolate
2.2. Experimental Procedure
2.2.1. Incubation and RGB Determination
2.2.2. Extraction and High-Performance Liquid Chromatography (HPLC)
2.3. Statistical Analysis
3. Results
4. Discussion
5. Conclusions
Author Contributions
Funding
Acknowledgments
Conflicts of Interest
References
- Weidenbörner, M. Encyclopedia of Food Mycotoxins, 1st ed.; Springer-Verlag Berlin Heidelberg: New York, NY, USA, 2001; p. XII, 294. [Google Scholar]
- Sobrova, P.; Adam, V.; Vasatkova, A.; Beklova, M.; Zeman, L.; Kizek, R. Deoxynivalenol and its toxicity. Interdiscip. Toxicol. 2010, 3, 94–99. [Google Scholar] [CrossRef] [PubMed]
- Rotter, B.A.; Prelusky, D.B.; Pestka, J.J. Toxicology of deoxynivalenol (vomitoxin). J. Toxicol. Environ. Health 1996, 48, 1–34. [Google Scholar] [CrossRef] [PubMed]
- Wilson, W.; Dahl, B.; Nganje, W. Economic costs of fusarium head blight, scab and deoxynivalenol. World Mycotoxin J. 2018, 11, 291–302. [Google Scholar] [CrossRef]
- Schmale, D.G., III; Munkvold, G.P. Mycotoxins in Crops: A Threat to Human and Domestic Animal Health. Available online: https://www.apsnet.org/edcenter/intropp/topics/mycotoxins/pages/economicimpact.aspx (accessed on 30 November 2018).
- Takenaka, H.; Kawamura, S.; Sumino, A.; Yano, Y. New combination use of gravity separator and optical sorter for decontamination deoxynivalenol of wheat. In Proceedings of the 5th International Technical Symposium on Food Processing, Monitoring Technology in Bioprocesses and Food Quality Management, Potsdam, Germany, 31 August–2 September 2009; Sun, D.-W., Ed.; ATB, Leibniz-Inst. für Agrartechnik: Potsdam, Germany; p. 978.
- Velluti, A.; Sanchis, V.; Ramos, A.J.; Turon, C.; Marín, S. Impact of essential oils on growth rate, zearalenone and deoxynivalenol production by fusarium graminearum under different temperature and water activity conditions in maize grain. J. Appl. Microbiol. 2004, 96, 716–724. [Google Scholar] [CrossRef] [PubMed]
- Ramirez, M.L.; Chulze, S.; Magan, N. Temperature and water activity effects on growth and temporal deoxynivalenol production by two argentinean strains of Fusarium graminearum on irradiated wheat grain. Int. J. Food Microbiol. 2006, 106, 291–296. [Google Scholar] [CrossRef]
- Hope, R.; Aldred, D.; Magan, N. Comparison of environmental profiles for growth and deoxynivalenol production by Fusarium culmorum and F. Graminearum on wheat grain. Lett. Appl. Microbiol. 2005, 40, 295–300. [Google Scholar] [CrossRef] [PubMed]
- Cambaza, E.M.; Koseki, S.; Kawamura, S. Meta-analytic review on the impact of temperature and water activity in deoxynivalenol synthesis by Fusarium graminearum. Food Res. 2018, 2, 443–446. [Google Scholar] [CrossRef]
- Leplat, J.; Friberg, H.; Abid, M.; Steinberg, C. Survival of Fusarium graminearum, the causal agent of fusarium head blight. A review. Agron. Sustain. Dev. 2013, 33, 97–111. [Google Scholar] [CrossRef]
- Garcia, D.; Ramos, A.J.; Sanchis, V.; Marin, S. Predicting mycotoxins in foods: A review. Food Microbial. 2009, 26, 757–769. [Google Scholar] [CrossRef]
- Cambaza, E.; Koseki, S.; Kawamura, S. The use of colors as an alternative to size in Fusarium graminearum growth studies. Foods 2018, 7. [Google Scholar] [CrossRef] [PubMed]
- Martins, M.L.; Martins, H.M. Influence of water activity, temperature and incubation time on the simultaneous production of deoxynivalenol and zearalenone in corn (Zea mays) by Fusarium graminearum. Food Chem. 2002, 79, 315–318. [Google Scholar] [CrossRef]
- Cambaza, E. Comprehensive description of Fusarium graminearum pigments and related compounds. Foods 2018, 7, 165. [Google Scholar] [CrossRef] [PubMed]
- Sugiura, Y. Gibberella zeae (schwabe) petch. In JCM Catalogue; Japan Collection of Microorganisms, Ed.; Microbe Division (JCM): Tsukuba, Japan, 1996. [Google Scholar]
- Sugiura, Y.; Watanabe, Y.; Tanaka, T.; Yamamoto, S.; Ueno, Y. Occurrence of Gibberella zeae strains that produce both nivalenol and deoxynivalenol. Appl. Environ. Microbiol. 1990, 56, 3047–3051. [Google Scholar] [PubMed]
- Schneider, C.A.; Rasband, W.S.; Eliceiri, K.W. NIH Image to ImageJ: 25 years of image analysis. Nat. Methods 2012, 9, 671–675. [Google Scholar] [CrossRef] [PubMed]
- Supel™ Tox SPE Cartridges: Fast and Simple Cleanup for Mycotoxin Analysis. Available online: https://www.sigmaaldrich.com/content/dam/sigma-aldrich/docs/Supelco/General_Information/1/T413026.pdf (accessed on 30 November 2018).
- Baker, P.M.; Roberts, J.C. Studies in mycological chemistry. Part XXI. The structure of aurofusarin, a metabolite of some Fusarium species. J. Chem. Soc. C Org. 1966, 2234–2237. [Google Scholar] [CrossRef]
- Ashley, J.N.; Hobbs, B.C.; Raistrick, H. Studies in the biochemistry of micro-organisms: The crystalline colouring matters of Fusarium culmorum (W. G. Smith) Sacc. and related forms. Biochem. J. 1937, 31, 385. [Google Scholar] [CrossRef] [PubMed]
- Kim, H.; Son, H.; Lee, Y.W. Effects of light on secondary metabolism and fungal development of Fusarium graminearum. J. Appl. Microbiol. 2014, 116, 380–389. [Google Scholar] [CrossRef] [PubMed]
- Shibata, S.; Morishita, E.; Takeda, T.; Sakata, K. The structure of aurofusarin. Tetrahedron Lett. 1966, 7, 4855–4860. [Google Scholar] [CrossRef]
- Avalos, J.; Pardo-Medina, J.; Parra-Rivero, O.; Ruger-Herreros, M.; Rodríguez-Ortiz, R.; Hornero-Méndez, D.; Limón, M.C. Carotenoid Biosynthesis in Fusarium. J. Fungi (Basel) 2017, 3. [Google Scholar] [CrossRef]
- Jin, J.-M.; Lee, J.; Lee, Y.-W. Characterization of carotenoid biosynthetic genes in the ascomycete Gibberella zeae. FEMS Microbiol. Lett. 2009, 302, 197–202. [Google Scholar] [CrossRef]
- Leeper, F.J.; Staunton, J. The biosynthesis of rubrofusarin, a polyketide naphthopyrone from Fusarium culmorum: 13C N.M.R. assignments and incorporation of 13C-and 2H-labelled acetates. J. Chem. Soc. Perkin Trans. 1 1984, 12, 2919–2925. [Google Scholar] [CrossRef]
- Garcia-Cela, E.; Kiaitsi, E.; Medina, A.; Sulyok, M.; Krska, R.; Magan, N. Interacting environmental stress factors affects targeted metabolomic profiles in stored natural wheat and that inoculated with F. Graminearum. Toxins 2018, 10, 56. [Google Scholar] [CrossRef] [PubMed]
- Ramirez, M.L.; Chulze, S.; Magan, N. Impact of environmental factors and fungicides on growth and deoxinivalenol production by Fusarium graminearum isolates from Argentinian wheat. Crop Prot. 2004, 23, 117–125. [Google Scholar] [CrossRef]
- Deacon, J.W. Fungal Biology, 4th ed.; Blackwell Pub.: Malden, MA, USA, 2006; p. 371. [Google Scholar]
- Frandsen, R.J.N.; Nielsen, N.J.; Maolanon, N.; Sørensen, J.C.; Olsson, S.; Nielsen, J.; Giese, H. The biosynthetic pathway for Aurofusarin in Fusarium graminearum reveals a close link between the naphthoquinones and naphthopyrones. Mol. Microbiol. 2006, 61, 1069–1080. [Google Scholar] [CrossRef]
- Avalos, J.; Estrada, A.F. Regulation by light in Fusarium. Fungal Genet. Biol. 2010, 47, 930–938. [Google Scholar] [CrossRef] [PubMed]
- Martín, J.-F.; García-Estrada, C.; Zeilinger, S. Biosynthesis and Molecular Genetics of Fungal Secondary Metabolites; Springer: Berlin, Germany, 2014. [Google Scholar]
- Medentsev, A.G.; Kotik, A.N.; Trufanova, V.A.; Akimenko, V.K. Identification of aurofusarin in Fusarium graminearum isolates, causing a syndrome of worsening of egg quality in chickens. Prikl. Biokhim. Mikrobiol. 1993, 29, 542–546. [Google Scholar] [PubMed]
- Diaz-Sanchez, V.; Estrada, A.F.; Trautmann, D.; Al-Babili, S.; Avalos, J. The gene card encodes the aldehyde dehydrogenase responsible for neurosporaxanthin biosynthesis in Fusarium fujikuroi. FEBS J. 2011, 278, 3164–3176. [Google Scholar] [CrossRef]
- Studt, L.; Wiemann, P.; Kleigrewe, K.; Humpf, H.-U.; Tudzynski, B. Biosynthesis of Fusarubins Accounts for Pigmentation of Fusarium fujikuroi Perithecia. Appl. Environ. Microbiol. 2012, 78, 4468–4480. [Google Scholar] [CrossRef]
- Frandsen, R.J.N.; Rasmussen, S.A.; Knudsen, P.B.; Uhlig, S.; Petersen, D.; Lysøe, E.; Gotfredsen, C.H.; Giese, H.; Larsen, T.O. Black perithecial pigmentation in Fusarium species is due to the accumulation of 5-deoxybostrycoidin-based melanin. Sci. Rep. 2016, 6, 26206. [Google Scholar] [CrossRef]
- Jarolim, K.; Wolters, K.; Woelflingseder, L.; Pahlke, G.; Beisl, J.; Puntscher, H.; Braun, D.; Sulyok, M.; Warth, B.; Marko, D. The secondary Fusarium metabolite aurofusarin induces oxidative stress, cytotoxicity and genotoxicity in human colon cells. Toxicol. Lett. 2018, 284, 170–183. [Google Scholar] [CrossRef]
- Frandsen, R.J.; Schutt, C.; Lund, B.W.; Staerk, D.; Nielsen, J.; Olsson, S.; Giese, H. Two novel classes of enzymes are required for the biosynthesis of aurofusarin in Fusarium graminearum. J. Biol. Chem. 2011, 286, 10419–10428. [Google Scholar] [CrossRef] [PubMed]
- Prado-Cabrero, A.; Scherzinger, D.; Avalos, J.; Al-Babili, S. Retinal biosynthesis in fungi: Characterization of the carotenoid oxygenase Carx from Fusarium fujikuroi. Eukaryot. Cell 2007, 6, 650–657. [Google Scholar] [CrossRef] [PubMed]
- 01497 Yeast Extract Agar. Available online: https://www.sigmaaldrich.com/content/dam/sigma-aldrich/docs/Sigma-Aldrich/Datasheet/1/01497dat.pdf (accessed on 30 November 2018).
- Sorensen, J.L.; Sondergaard, T.E. The effects of different yeast extracts on secondary metabolite production in fusarium. Int. J. Food Microbiol. 2014, 170, 55–60. [Google Scholar] [CrossRef] [PubMed]
- Bennett, J.W.; Klich, M. Mycotoxins. Clin. Microbiol. Rev. 2003, 16, 497–516. [Google Scholar] [CrossRef] [PubMed]

| RGB Channel | pANCOVA | aw | Post hoc Color Comparison | |||||
|---|---|---|---|---|---|---|---|---|
| Mean Difference | SE | df | t | pTukey | ||||
| R | 0.169 | 0.94 | 0.97 | 0.02 | 0.03 | 8 | 0.63 | 0.809 |
| 0.99 | 0.06 | 0.03 | 8 | 2.06 | 0.159 | |||
| 0.97 | 0.99 | 0.04 | 0.03 | 8 | 1.44 | 0.369 | ||
| G | 0.007 | 0.94 | 0.97 | 0.02 | 0.01 | 6 | 2.22 | 0.145 |
| 0.99 | 0.07 | 0.01 | 6 | 8.06 | < .001 | |||
| 0.97 | 0.99 | 0.05 | 0.01 | 6 | 5.84 | 0.003 | ||
| B | 0.02 | 0.94 | 0.97 | 0.03 | 0.04 | 8 | 0.69 | 0.778 |
| 0.99 | 0.13 | 0.04 | 8 | 3.43 | 0.022 | |||
| 0.97 | 0.99 | 0.1 | 0.04 | 8 | 2.74 | 0.059 | ||
© 2018 by the authors. Licensee MDPI, Basel, Switzerland. This article is an open access article distributed under the terms and conditions of the Creative Commons Attribution (CC BY) license (http://creativecommons.org/licenses/by/4.0/).
Share and Cite
Cambaza, E.; Koseki, S.; Kawamura, S. Fusarium graminearum Colors and Deoxynivalenol Synthesis at Different Water Activity. Foods 2019, 8, 7. https://doi.org/10.3390/foods8010007
Cambaza E, Koseki S, Kawamura S. Fusarium graminearum Colors and Deoxynivalenol Synthesis at Different Water Activity. Foods. 2019; 8(1):7. https://doi.org/10.3390/foods8010007
Chicago/Turabian StyleCambaza, Edgar, Shigenobu Koseki, and Shuso Kawamura. 2019. "Fusarium graminearum Colors and Deoxynivalenol Synthesis at Different Water Activity" Foods 8, no. 1: 7. https://doi.org/10.3390/foods8010007
APA StyleCambaza, E., Koseki, S., & Kawamura, S. (2019). Fusarium graminearum Colors and Deoxynivalenol Synthesis at Different Water Activity. Foods, 8(1), 7. https://doi.org/10.3390/foods8010007







